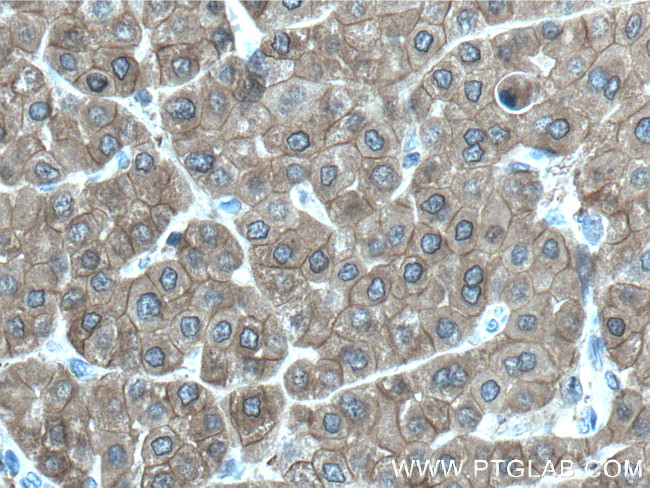
UGP2 Antibody in Immunohistochemistry (Paraffin) (IHC (P))

Search
Proteintech
UGP2 Polyclonal Antibody
{{$productOrderCtrl.translations['antibody.pdp.commerceCard.promotion.promotions']}}
{{$productOrderCtrl.translations['antibody.pdp.commerceCard.promotion.viewpromo']}}
{{$productOrderCtrl.translations['antibody.pdp.commerceCard.promotion.promocode']}}: {{promo.promoCode}} {{promo.promoTitle}} {{promo.promoDescription}}. {{$productOrderCtrl.translations['antibody.pdp.commerceCard.promotion.learnmore']}}
产品信息
10391-1-AP
种属反应
已发表种属
宿主/亚型
分类
类型
抗原
偶联物
形式
浓度
规格
纯化类型
保存液
内含物
保存条件
运输条件
产品详细信息
Immunogen sequence: SQDGASQFQ EVIRQELELS VKKELEKILT TASSHEFEHT KKDLDGFRKL FHRFLQEKGP SVDWGKIQRP PEDSIQPYEK IKARGLPDNI SSVLNKLVVV KLNGGLGTSM GCKGPKSLIG VRNENTFLDL TVQQIEHLNK TYNTDVPLVL MNSFNTDEDT KKILQKYNHC RVKIYTFNQS RYPRINKESL LPVAKDVSYS GENTEAWYPP GHGDIYASFY NSGLLDTFIG EGKEYIFVSN IDNLGATVDL YILNHLMNPP NGKRCEFVME VTNKTRADVK GGTLTQY (2-287 aa encoded by BC002954)
靶标信息
The enzyme encoded by this gene is an important intermediary in mammalian carbohydrate interconversions. It transfers a glucose moiety from glucose-1-phosphate to MgUTP and forms UDP-glucose and MgPPi. In liver and muscle tissue, UDP-glucose is a direct precursor of glycogen; in lactating mammary gland it is converted to UDP-galactose which is then converted to lactose. The eukaryotic enzyme has no significant sequence similarity to the prokaryotic enzyme. Two transcript variants encoding different isoforms have been found for this gene.
仅用于科研。不用于诊断过程。未经明确授权不得转售。
生物信息学
蛋白别名: testis tissue sperm-binding protein Li 58p; UDP-glucose diphosphorylase; UDP-glucose pyrophosphorylase; UDP-glucose pyrophosphorylase 1; UDPGP; UGPase 2; unnamed protein product; uridindiphosphoglucosepyrophosphorylase 2; uridyl diphosphate glucose pyrophosphorylase 2; Uridyl diphosphate glucose pyrophosphorylase-1; UTP--glucose-1-phosphate uridylyltransferase; UTP--glucose-1-phosphate uridylyltransferase 2; UTP-glucose-1-phosphate uridyltransferase
基因别名: DEE83; EIEE83; pHC379; SVUGP2; UDPG; UDPGP; UDPGP2; UGP1; UGP2; UGPase; UGPP1; UGPP2
UniProt ID: (Human) Q16851, (Mouse) Q91ZJ5
Entrez Gene ID: (Human) 7360, (Rat) 289827, (Mouse) 216558